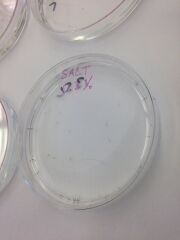
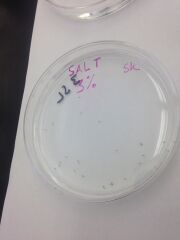
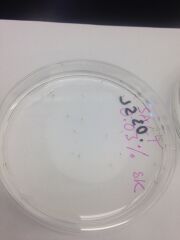

Uploads by Pamela Huber
From OpenWetWare
Jump to navigationJump to search
This special page shows all uploaded files.
| Date | Name | Thumbnail | Size | Description |
|---|---|---|---|---|
| 20:54, 9 March 2014 | Day4sample1.jpg (file) |  |
102 KB | |
| 20:54, 9 March 2014 | Day4sample2.jpg (file) |  |
102 KB | |
| 20:53, 9 March 2014 | Day4sample3.jpg (file) | |
110 KB | |
| 20:53, 9 March 2014 | Day4sample4.jpg (file) | |
98 KB | |
| 20:51, 9 March 2014 | Day4allsamples.jpg (file) |  |
108 KB | |
| 20:50, 9 March 2014 | Day7sample1point3.jpg (file) |  |
114 KB | |
| 20:50, 9 March 2014 | Day7sample2.jpg (file) | |
97 KB | |
| 20:49, 9 March 2014 | Day7sample3.jpg (file) |  |
100 KB | |
| 20:47, 9 March 2014 | Day7sample4.jpg (file) |  |
97 KB | |
| 20:46, 9 March 2014 | Day7sample1point2.jpg (file) |  |
103 KB | |
| 20:44, 9 March 2014 | Day7sample1.jpg (file) |  |
56 KB | |
| 19:02, 2 March 2014 | Transect5Foodweb.jpg (file) |  |
137 KB | |
| 18:29, 2 March 2014 | Beetle1.jpg (file) |  |
52 KB | |
| 18:27, 2 March 2014 | Tiny.jpg (file) |  |
55 KB | |
| 18:25, 2 March 2014 | CentipedeAndSpider.jpg (file) |  |
71 KB | |
| 18:00, 2 March 2014 | 7Dilutions.jpg (file) |  |
166 KB | |
| 17:59, 2 March 2014 | Transect5.jpg (file) |  |
163 KB | |
| 17:49, 2 March 2014 | 7Dishes.jpg (file) |  |
13 KB | |
| 19:58, 23 February 2014 | PlantKey.jpg (file) |  |
94 KB | |
| 19:58, 23 February 2014 | PlantSamples.jpg (file) |  |
97 KB | |
| 19:57, 23 February 2014 | FUNGI.jpg (file) |  |
34 KB | |
| 11:12, 10 February 2014 | Dilution.jpg (file) |  |
31 KB | |
| 10:58, 10 February 2014 | BT2.jpg.jpg (file) |  |
16 KB | |
| 10:57, 10 February 2014 | BT1.jpg.jpg (file) |  |
253 KB | |
| 10:57, 10 February 2014 | E2.jpg.jpg (file) |  |
28 KB | |
| 10:57, 10 February 2014 | E1.jpg.jpg (file) |  |
16 KB |